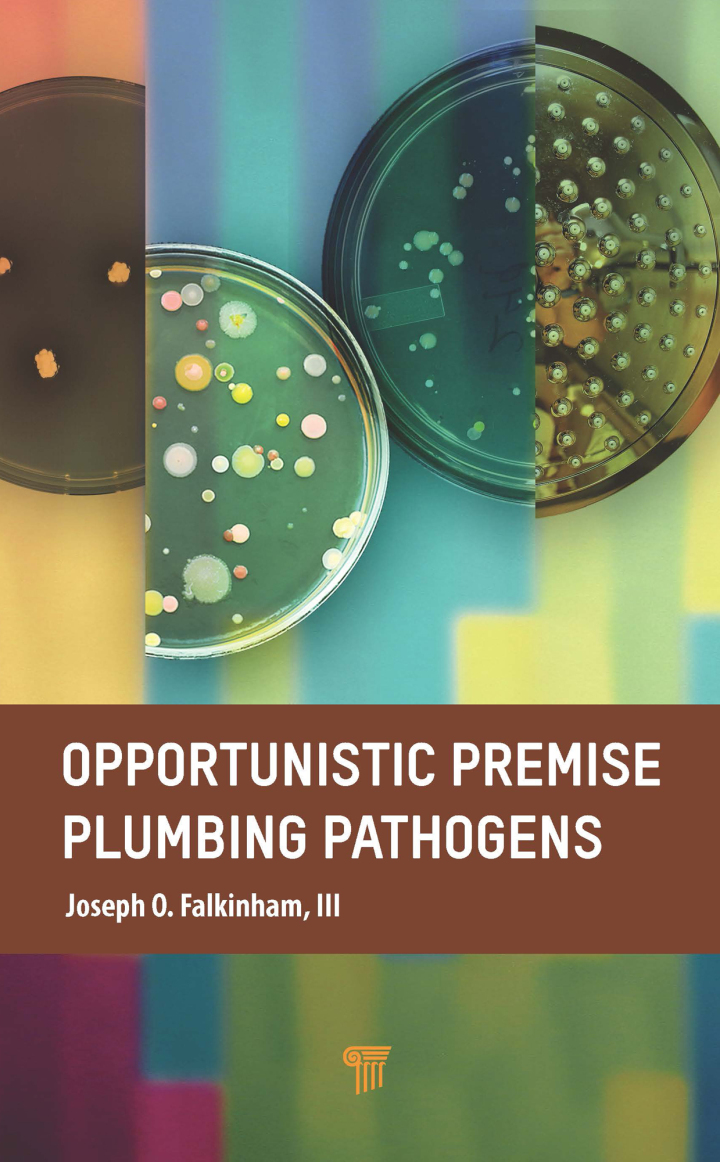

Opportunistic Premise Plumbing Pathogens 1st Edition
Opportunistic Premise Plumbing Pathogens, 1st Edition by Joseph O. Falkinham, III delivers a definitive, research-driven guide to understanding and managing waterborne microbes in building plumbing systems. This compelling resource draws you in with clear explanations of how bacteria, amoebae, and other opportunistic pathogens colonize pipes, fixtures, and storage tanks — and why that matters for health and infrastructure.
Combining rigorous science with practical relevance, the book explains the ecology, detection methods, and risk factors of organisms such as Legionella and non-tuberculous mycobacteria. Readers will find accessible discussions of biofilm formation, water chemistry, temperature effects, and the role of stagnation and materials in pathogen growth — essential knowledge for anyone responsible for safe water in the built environment.
Designed for facility managers, water quality professionals, public health officials, engineers, and researchers across hospitals, hotels, schools, and municipal buildings worldwide, this volume equips you with actionable strategies for monitoring, prevention, and control. Learn how to interpret test results, prioritize interventions, and integrate plumbing pathogen management into broader water safety plans.
If you need an authoritative reference that bridges microbiology and applied plumbing practice, Joseph O. Falkinham’s work is a must-have. Enhance your building’s water safety and compliance with expert insight and straightforward recommendations. Order your copy today to strengthen your pathogen risk management and protect occupants in any region or climate.